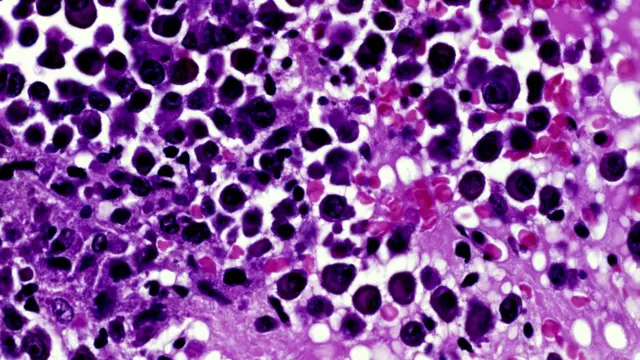
Рак крови

Рак может быть излечим, утверждают британские ученые

Автор фото, Getty Images
Британские ученые сообщили, что в течение ближайших 10 лет могут быть разработаны новые препараты, способные останавливать развитие самых стойких раковых клеток, не реагирующих на другие процедуры.
Британский Институт исследования рака (ICR) объявил, что выделяет 75 млн фунтов стерлингов на изучение этого подхода.
ICR надеется открыть современный центр разработки новых лекарств в лондонском районе Саттон, на юге столицы.
Глава института Пол Уоркман сказал, что самой серьезной проблемой в борьбе с раком остается способность раковых клеток адаптироваться к лекарствам и вырабатывать лекарственную устойчивость.
По его словам, новые лекарства, находящиеся в стадии разработки, смогут сдерживать распространение рака в долгосрочной перспективе, кроме того, от рака можно будет чаще излечиться.
Нечто подобное уже происходит с пациентами, зараженными вирусом ВИЧ.
Исследователи говорят, что современные методы борьбы с онкологическими заболеваниями, например, химиотерапия, иногда не приносят результатов, так как раковые клетки выживают, адаптируются, и рак возвращается.
"Способность раковых клеток эволюционировать и развивать резистенцию - главная причина большинства смертей от рака и основная проблема в борьбе с этим заболеванием", - говорит профессор Уоркман.
По его словам, ICR разрабатывает радикально новый подход к лечению рака, пытаясь заранее предугадать, как именно будут эволюционировать раковые клетки. Задача исследователей - не позволить раковым клеткам вырабатывать устойчивость к противораковым препаратам.
Институт надеется привлечь к работе над проектом работали около 300 исследователей из разных сфер науки.

Анализ
Джеймс Галлахер, корреспондент Би-би-си по вопросам науки и здоровья
Все виды рака постоянно эволюционируют. Это представляет серьезную проблему, так как рак может вернуться, если раковые клетки развивают устойчивость к курсу лечения.
Институт исследования рака IRC надеется использовать этот процесс эволюции в поисках новых видов терапии.
Автор фото, Science Photo Library
Среди прочего, исследователи надеются разработать лекарство, которое ограничивало бы процесс эволюции раковых клеток и опухолей, или же усиливало действие лекарств.
Одновременное применение сразу нескольких препаратов также может оказаться непреодолимым для раковых клеток.
На ранних стадиях этих исследований были обнаружены позитивные результаты, но до их применения на практике пройдет не меньше 10 лет.
Ученые надеются, что новые подходы к лечению рака принесут плоды. Среди прочего, речь идет об использовании сразу нескольких лекарственных препаратов, а также программы искусственного интеллекта для того, чтобы научиться предсказывать и предотвращать эволюцию раковых клеток.
Большая продолжительность жизни
Глава нового исследовательского центра доктор Андреа Сотторива говорит, что искусственный интеллект и математические прогностические методы могут понять, как ведут себя раковые клетки и как они отреагируют на новые методы лечения.
Исследователи уже разрабатывают новые препараты для того, чтобы остановить работу молекулы белка APOBEC, которая является частью иммунной системы, и именно эту молекулу берут под свой контроль более половины разных клеток рака, что позволяет им сопротивляться иммунной системе.
"Мы твердо уверены, что благодаря дополнительным исследованиям мы найдем способы держать рак под контролем в долгосрочной перспективе, и даже вылечивать пациентов, которые будут жить дольше с лучшим качеством жизни", - говорит профессор Уоркман.






















